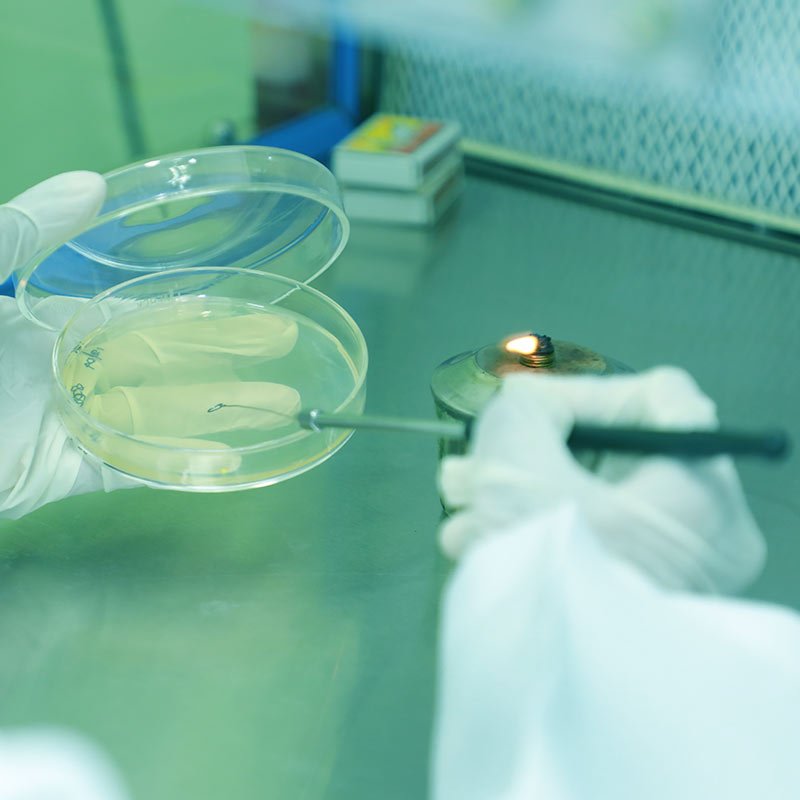

production.packing.storage
Sahana Pharmaceuticals
facility
Facility
production . packing . storage
sahana Pharma was located around the greeneries plot and road with the total area of 1102. 78 square meter. This particular area is granted to do the formulation and testing of tablets. Our supplies are highly qualified and the product are really good for the patients.
PRODUCTION FACILITY
The product are manufacture in the form of tablet and all the formulation was produce in the sahana pharmaceuticals. The products are consists as the following section
- Dispensing
- Granulation
- Inprocess
- Compression
- Coating
- Packing
- Washing area
PACKING FACILITY
The Quality Assurance department check the records of the product and after the proper verification they released the product. The true product are carried out with shield through the vehicle and distributed.
Our product packing was takes place in many types based on their delivery.
- Blister Packing
- Alu Alu Packing
- Strip Packing
- Online Packing bay
- Despatch Section
STORAGE FACILITY
We store our raw materials packed product in many areas based on their toxic. There the product are testified and stored, some of them rejected.
The products are visit many places like sampling area, under test area, rejection store, separative active and inactive area, primary packing and material store, dispensing area, secondary packing materials. Finally they reached in the main store and ready for the package.
DISPENSING
Dispensing the right materials to the right batches prior to the manufacturing process is a key activity in life sciences and other process industries. The process is critical when working with potent active pharmaceutical ingredients (APIs) in drug manufacturing.
GRANULATION
Granulation is the process of forming of grains or granules from a powdery or solid substance, producing a granular material. It is applied in several technological processes in chemical and pharmaceutical industry
COMPRESSION
The sizing (size reduction, milling, crushing, grinding, pulverization) is an important step in the process of tablet manufacturing. In manufacturing ofcompressed tablets, the mixing or blending of several solid pharmaceutical ingredients is easier and more uniform if the ingredients are about the same size.
INPROCES CONTROL
Checks performed during production to monitor and, if appropriate, to adjust the process to ensure that the intermediate or API (drug substance) conforms to its specifications and/or other defined quality criteria.
COATING
Coating is a process by which an essentially dry, outer layer of coating material is applied to the surface of a dosage form in order to confer specific benefits that broadly ranges from facilitating product identification to modifying drug release from the dosage form.
PACKAGING
Packaging also refers to the process of designing, evaluating, and producing packages. Packaging can be described as a coordinated system of preparing goods for transport, warehousing, logistics, sale, and end use. Packaging contains, protects, preserves, transports, informs, and sells.
WATER PLANT
In our sahana pharmaceuticals, we using the highly technical water purification plant, In our manufacturing process, we using the house water purification plant. We using nine steps to generated the house plant purification.
AIR HANDLING SYSTEM
For maintaining the room temperature, we using the Air Handling Units. We use more than 13 double skin air handling units. In our area of production, store and microbiology lab we provide Air Handling System. We design the ventilation system based on the recirculation of air at 90% and 10% of fresh air. We using four types of filtering process based on that the air enter to the Air Handling System.
ENGINEERING AND MAINTENANCE
In our industry the engineering and maintenance department are always aware about the duty. They daily check every equipment and do their job in a best way.
AIR HANDLING SYSTEM
AIR COMPRESSOR
AHU & CHILLER
WATER PLANT
AIR HANDLING SYSTEM
About Sahana
Sahana Pharmaceuticals commissioned in the year of 2014 at the heart of Kanyakumari district. We are engaged in manufacturing and marketing varied formulations of Tablets in 2015. Sahana strives to provide high-quality pharmaceutical products that improve the health of the patients.
Location
SAHANA PHARMACEUTICALS (P) LTD
No :20/72/4 Main Road,
Melakattuvilai Maniketipottal (P.O)
Kanyakumari (Dist) Pin- 629501
(+91) 9488887794
+914652-286661,
Products
Newsletter
Get Social
© Copyright 2019 Sahana Pharmaceuticals Pvt Ltd.
All rights reserved & Powered by LezDo TechMed